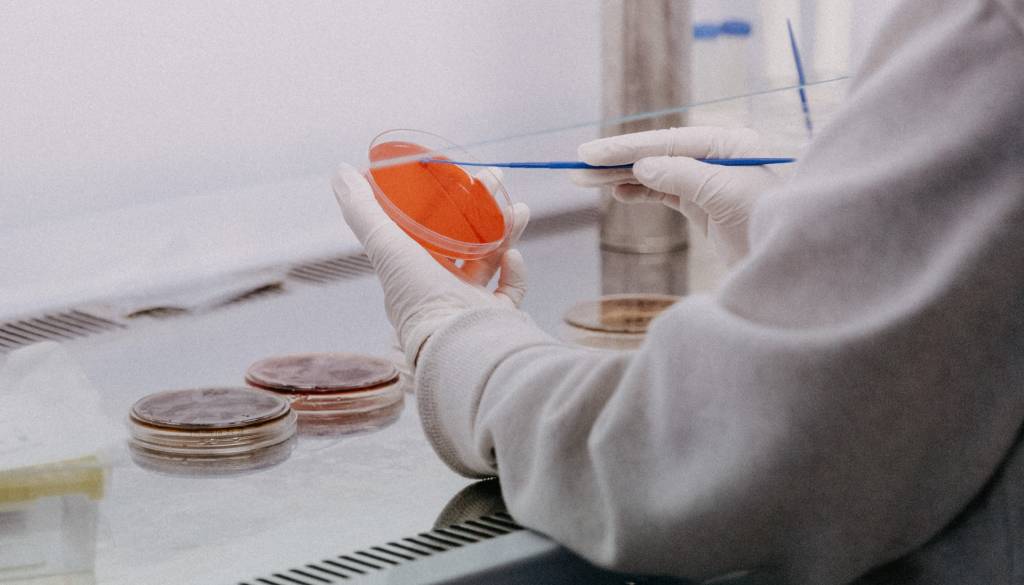

Koronavirus naj bi na človeka prišel preko živali gostiteljice, možnosti, da bi virus ušel iz laboratorija, tudi niso povsem izključili.
Mednarodni strokovnjaki pod okriljem Svetovne zdravstvene organizacije (WHO) in njihovi kitajski kolegi so ugotovili, da je verjetno do zelo verjetno, da se je novi koronavirus na človeka prenesel z netopirja prek druge živali gostiteljice. Tudi možnosti, da bi virus ušel iz laboratorija, niso povsem izključili.
Virus preskočil na žival, ki je okužila ljudi
Strokovnjaki verjamejo, da virus sars-cov-2, ki povzroča koronavirusno bolezen 19, izvira iz netopirjev. Ena od hipotez, ki so jih proučevali, je, da je virus preskočil neposredno z netopirjev na ljudi. Ta teorija je »možna do verjetna«, piše v končnem poročilu, ki ga je pridobila francoska tiskovna agencija AFP, piše STA.
Po mnenju strokovnjakov, je verjetnejša hipoteza, da je virus najprej preskočil na drugo žival, ki je nato okužila ljudi.
»Čeprav so bili najtesneje povezani virusi najdeni v netopirjih, je evolucijska razdalja med temi virusi v netopirjih in virusom sars-cov-2 ocenjena na več desetletij, kar kaže na manjkajočo povezavo,« so pojasnili.
Možen prenos tudi prek zamrznjene hrane
Kot piše STA, je scenarij, ki vključuje prenos prek vmesnega gostitelja, verjeten do zelo verjeten. Prek katere živali je virus preskočil na človeka, sicer niso ugotovili, je zapisano v poročilu, ki še ni bilo uradno objavljeno.
Po njihovih besedah je možen tudi prenos prek zamrznjene hrane, saj se zdi, da lahko virus preživi na temperaturah pod lediščem.
Strokovnjaki so pozvali k nadaljnjim raziskavam na podlagi teh treh teorij. Pri tem je treba obravnavati širše območje in več držav, so poudarili.
Je virus ušel iz laboratorija?
Proučevali so sicer tudi možnost, da bi novi koronavirus ušel iz laboratorija, kar je trdil nekdanji ameriški predsednik Donald Trump.
Pojasnili so, da pred decembrom 2019 v laboratorijih ni bilo virusa, ki bi spominjal na sars-cov-2. Izpostavili so tudi visoke varnostne standarde v laboratorijih v kitajskem Wuhanu.
Strokovnjaki poudarjajo, da je laboratorijski izvor virusa zelo malo verjeten, še piše STA.